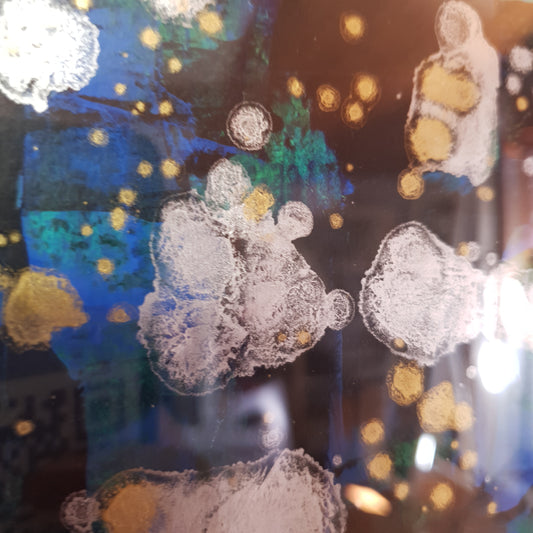
Dipinto originale su carta, Licurici

Osa essere Originale

Calice
Scopri l’arte dei sensi: Degustazione di Vini Locali e Laboratorio di Pittura Astratta Un’esperienza unica che unisce il piacere del palato con la creatività. Ti invitiamo a partecipare a una degustazione esclusiva di vini locali, sapientemente selezionati per accompagnarti in un viaggio sensoriale indimenticabile. Mentre assapori i pregiati vini, un esperto ti guiderà in un laboratorio di pittura astratta, dove l’emozione di ogni sorso ispirerà il tuo tocco creativo

Atenzione
Per un esperienza a regola d'arte è consigliato di soffermarsi e ammirare per un minimo di 3 minuti per ogni opera. GRAZIE

Il Slogan
Il progetto “Osa essere Originale” celebra l’individualità e l’autenticità nell’arte. Si oppone alla cultura di massa, valorizzando le scelte personali e l’unicità. L’essenza del progetto è di incoraggiare le persone a distinguersi, accettando e amando se stessi in un mondo dominato dai trend. Si sottolinea l’importanza di essere unici, originali e rari, sia nella creazione che nel possesso di opere d’arte, promuovendo l’autenticità e la rarità come valori fondamentali. Possedere un opera d'arte, un dipinto piccolo originale è naturale come possedere la propria identità. Vedi la sezione blog
La più amata collezione
-
Dipinto dittico originale su carta, Acqua e Sale
Produttore:Larisa Art TintaPrezzo di listino €0,00Prezzo di listino -
Dipinto dittico originale su carta,Giostra
Produttore:Larisa Art TintaPrezzo di listino €0,00Prezzo di listino -
Dipinto originale su carta, Arcevia
Produttore:Larisa Art TintaPrezzo di listino €0,00Prezzo di listino -
Dipinto dittico originale su carta, Garagolo
Produttore:Larisa Art TintaPrezzo di listino €0,00Prezzo di listino -
Dipinto dittico originale su carta, Senigallia by Night
Produttore:Larisa Art TintaPrezzo di listino €0,00Prezzo di listino -
Dipinto dittico originale si carta, Lungomare
Produttore:Larisa Art TintaPrezzo di listino €0,00Prezzo di listino -
Dipinto dittico originale su carta, Ascoltando un rosa Blu
Produttore:Larisa Art TintaPrezzo di listino €0,00Prezzo di listino -
Dipinto dittico originale su carta, Jesi
Produttore:Larisa Art TintaPrezzo di listino €0,00Prezzo di listino -
Dipinto dittico originale su carta, Luna rosa
Produttore:Larisa Art TintaPrezzo di listino €0,00Prezzo di listino -
Dipinto originale su carta, Una notte d'estate
Produttore:Larisa Art TintaPrezzo di listino €0,00Prezzo di listino -
Dipinto originale su carta, Agosto
Produttore:Larisa Art TintaPrezzo di listino €0,00Prezzo di listino -
Dipinto originale su carta, dittico ,Montecarotto
Produttore:Larisa Art TintaPrezzo di listino €0,00Prezzo di listino -
Dipinto originale su carta, dittico Persone
Produttore:Larisa Art TintaPrezzo di listino €0,00Prezzo di listino -
Dipinto originale su carta, dittico, Ricordi un bell ricordo
Produttore:Larisa Art TintaPrezzo di listino €0,00Prezzo di listino -
Dipinto originale su carta, Festa
Produttore:Larisa Art TintaPrezzo di listino €0,00Prezzo di listino -
Dipinto originale su carta, Licurici
Produttore:Larisa Art TintaPrezzo di listino €0,00Prezzo di listino -
Dipinto originale su carta, Luglio 2024
Produttore:Larisa Art TintaPrezzo di listino €0,00Prezzo di listino -
Dipinto originale su carta, Maggio
Produttore:Larisa Art TintaPrezzo di listino €0,00Prezzo di listino -
Dipinto originale su carta, Papaveri d'aprile
Produttore:Larisa Art TintaPrezzo di listino €0,00Prezzo di listino -
Dipinto originale su carta, Ritorno al
Produttore:Larisa Art TintaPrezzo di listino €0,00Prezzo di listino -
Dipinto originale su carta, Schermo
Produttore:Larisa Art TintaPrezzo di listino €0,00Prezzo di listino -
Dipinto originale su carta, Tracce
Produttore:Larisa Art TintaPrezzo di listino €0,00Prezzo di listino -
Dipinto su carta, dittico Giostra 2
Produttore:Larisa Art TintaPrezzo di listino €0,00Prezzo di listino -
Set 2 Dipinti su carta con cornice, Due dittico
Produttore:Larisa Art TintaPrezzo di listino €0,00Prezzo di listino -
Set 3 dipinti originali su carta, Estate mia trittico
Produttore:Larisa Art TintaPrezzo di listino €0,00Prezzo di listino
e.......La più Famosa
-
Specchio, originale dipinto a mano, Shalbby con manico, Rain of fame
Prezzo di listino €0,00Prezzo di listino -
Borsetta originale nero dipinta a mano, Rain of Fame
Prezzo di listino €0,00Prezzo di listino -
Borsetta originale bianca dipinta a mano, Rain of Fame
Prezzo di listino €0,00Prezzo di listino -
Dipinto originale, Rain of Fame
Prezzo di listino €0,00Prezzo di listino

Un Passione innato per il Colore
Larisa è una donna che nasce come make-up artist e ha una grande passione per la pittura e la creatività. Si è posta una sfida: creare 40 dipinti prima di compiere 40 anni. Chiama il suo progetto “40until40”, perché vuole rappresentare le sfumature della sua vita, le sue emozioni, i suoi sogni, le sue paure, le sue gioie. Larisa Tinta ha iniziato a dipingere per divertimento e poi ha frequentato alcuni corsi di pittura e sperimentato vari stili, dal figurativo all’astratto, dal pop art al surrealismo. Ha utilizzato diversi supporti, come tela, legno o metallo, e diversi media, come acrilico, guazzetti, pennarelli, inchiostri e altro ancora. Vedi intero articolo qui

Dipinti su carta
Vedi tuttoCreazioni vari

Braccialetto legno, dipinto a mano, Inverno, Largo

Vasi, Dipinti , Accessori e Creazioni Originali
Questa collezione e una raccolta di creazioni Originali. Un misto vibrazioni di...
I nostri servizi
-

Viaggio nell'Astratto
Il Significato dell'Astratto è la Libertà
Il Viaggio nell'Astratto di Larisa è un'esperienza che ogni individuo può vivere da solo o in coppia, può anche essere un'esperienza collettiva.
In lingua: Italiano, inglese e rumeno
Più info vedi contatti
Tutto il materiale fornito
Vedi anche l'articolo di blog qui
-

Creazione su misura
Dipinto o scultura astratta personalizzato
Se cerchi qualcosa di veramente unico , la nostra artista può creare un dipinto astratto personalizzato basato sulle tue preferenze di colore, tema e sensazioni che vuoi trasmettere. Porta a casa un'opera d'arte che rispecchia perfettamente la tua visione e i tuoi gusti. I tempi per la produzione varia in base alle dimensioni
-

Viaggio Sensoriale nell'Astratto
Un’esperienza immersiva a 360 gradi che risveglia i sensi e libera la creatività. Immagina di entrare in uno spazio dove il tempo rallenta e ogni percezione si amplifica. Il Viaggio Sensoriale nell’Astratto è un percorso artistico e sensoriale pensato per chi desidera esplorare l’arte non solo con gli occhi, ma con tutto il corpo e l’anima.
scopri di più Click > qui

Ormone
Ormone DNA "l'arte di Larisa è un potente esempio di come la creatività possa essere utilizzata per esplorare e comprendere meglio il nostro corpo. Le sue opere sul DNA ormonale non solo riflettono la sua passione per i cristalli e la pittura, ma anche la sua determinazione a trasformare una sfida personale in una fonte di ispirazione e conoscenza per gli altri. "